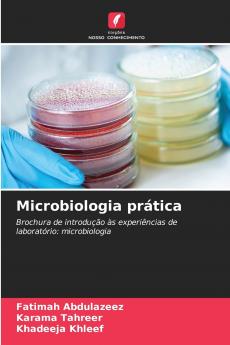
Microbiologia prática

Portuguese
Paperback
₹5161
₹7127
27.59% OFF
(All inclusive*)
Delivery Options
Please enter pincode to check delivery time.
*COD & Shipping Charges may apply on certain items.
Review final details at checkout.
Looking to place a bulk order? SUBMIT DETAILS
Delivery Options
Please enter pincode to check delivery time.
*COD & Shipping Charges may apply on certain items.
Review final details at checkout.
About The Book
Description
Author(s)
O livro é um manual de laboratório centrado em experiências de microbiologia especificamente relacionadas com a identificação e caraterização de espécies de Mycobacterium incluindo M. tuberculosis. Inclui vários testes como o teste do vermelho neutro a atividade da catalase a suscetibilidade à pirazinamida o teste da amidase e o teste de redução do nitrato detalhando as propriedades bioquímicas destas bactérias. Além disso aborda os métodos de filtração bacteriana a utilização de desinfectantes como o etanol e o isopropanol e a radiação para esterilização. No geral serve como um guia prático para estudantes e investigadores em microbiologia.
Details
ISBN 13
9786208767563
Publication Date
-21-03-2025
Pages
-60
Weight
-95 grams
Dimensions
-152x229x3.65 mm